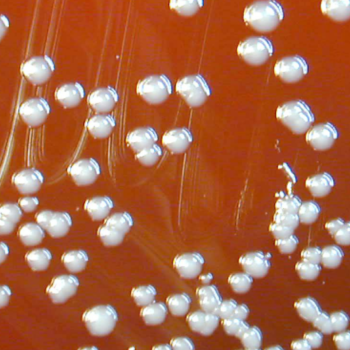

Alphabetical Index
Overview of the Microbe Beauveria bassiana (Balsamo) Vuillemin is an anamorphic ascomycete belonging to the family Cordycipitaceae, order Hypocreales, and is ubiquitously present in soil...
Overview of the Microbe Taxonomy and Strain Information Beijerinckia mobilis belongs to the domain Bacteria, phylum Pseudomonadota, class Alphaproteobacteria, order Hyphomicrobiales, and family Beijerinckiaceae[3]. The...
Bacillus subtilis is a robust, Gram-positive bacterium widely recognized for its adaptability and efficiency in various environments.
Overview of the Microbe Burkholderia cepacia belongs to the Burkholderia cepacia complex (Bcc), a group of at least 20 closely related Gram‑negative, catalase‑positive, lactose‑nonfermenting species within...
Overview of the Microbe Burkholderia vietnamiensis is a Gram‑negative, rod‑shaped bacterium first described by Gillis and colleagues in 1995 as part of the Burkholderia cepacia complex[1]. Unlike...
Overview of the Microbe Coniothyrium minitans, also known by the synonym Paraphaeosphaeria minitans, is an ascomycete fungus in the family Didymosphaeriaceae [1]. This obligate mycoparasite...
Overview of the Microbe Derxia gummosa is a gram-negative, rod-shaped, obligate aerobic bacterium recognized for its capacity to fix atmospheric nitrogen [1]. First described in...
Overview of the Microbe Enterobacter cloacae is a gram-negative, facultatively anaerobic, rod-shaped bacterium belonging to the family Enterobacteriaceae. Initially recognized for its opportunistic pathogenicity in...
Overview of the Microbe Enterobacter is a diverse genus of Gram-negative, rod-shaped, facultatively anaerobic bacteria within the Enterobacteriaceae family. These bacteria are widely distributed in...
Overview of the Microbe Flavobacterium columnare is a Gram-negative, rod-shaped, filamentous bacterium that belongs to the phylum Bacteroidetes and class Flavobacteriia. It is the etiological...
A pioneering expert in microbiological innovation, she specializes in applied and environmental microbiology, electromicrobiology, geomicrobiology, bioremediation, and synthetic biology. Her work advances sustainable solutions across ecosystems and industries, harnessing microbial processes to address pressing challenges in environmental health, energy, and biotechnology.
Overview of the Microbe Gliocladium virens (teleomorph: Trichoderma virens) is a filamentous, soil-dwelling fungus well recognized for its ability to suppress a wide array of...
Overview of the Microbe Gluconacetobacter diazotrophicus (formerly Acetobacter diazotrophicus) is a Gram-negative, strictly aerobic, non-spore-forming, rod-shaped bacterium belonging to the family Acetobacteraceae within Alphaproteobacteria. It...
The Global Launch of a New Scientific Frontier
Date: July 15-18, 2026
Time: 9am UTC (Everyday)
A pioneering industrial microbiologist who bridges food science and sustainability. Renowned for work in food safety, she develops innovative solutions for sustainable food systems, industrial practices, and microbial research.